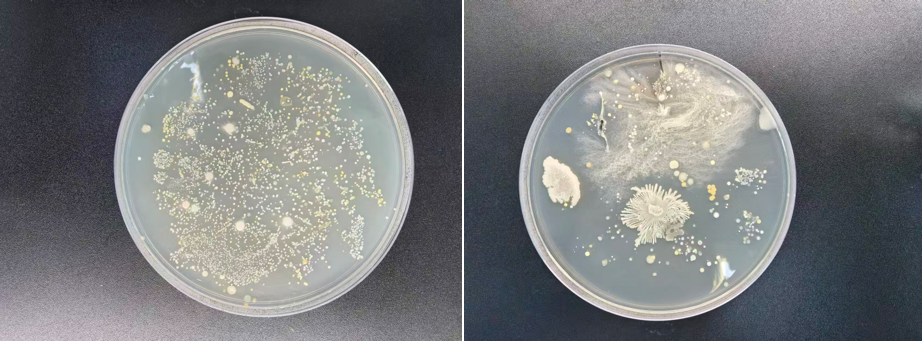

探秘微观居民 解锁生命奥秘——我校科技节系列活动之微生物科普讲座圆满举办
为激发学生对生命科学的好奇心与探索欲,拓宽科学视野,2025 年 11 月 24 日上午 8:20-9:00,我校科技节系列活动之 "探秘微观居民:从识别到初识内共生" 科普讲座在校园顺利开展。本次活动特别邀请到北京师范大学生命科学学院高级实验师郝晓冉老师担任主讲,为同学们带来了一场生动有趣的微生物知识盛宴。


郝晓冉老师长期深耕微生物学教学与研究领域,不仅是国家级一流本科课程负责人,还在国际基因工程机器人大赛指导、科研课题研究等方面成果丰硕。讲座中,郝老师以肠道微生物前沿研究为切入点,用通俗易懂的语言向同学们介绍了人类内共生微生物的组成与功能,将抽象的科学概念转化为贴近生活的知识要点。
为了让同学们直观感受微观世界的奇妙,讲座设置了实物观察与图片展示环节。郝老师通过清晰的图像资料,展示了细菌、真菌等常见微生物的菌落特征与细胞形态,详细讲解了 "细菌是单细胞原核微生物,形态多样"“真菌分为单细胞和多细胞两类,部分可形成菌丝体” 等核心知识,还介绍了通过菌落的形状、颜色、边缘、质地等宏观特征初步识别微生物类群的方法,让同学们了解到这些 "看不见的居民" 其实与我们的生活息息相关。
互动环节中,同学们带着浓厚的兴趣积极提问,郝老师耐心解答了 "微生物在哪里生活"" 它们对我们有什么影响 " 等问题,引导同学们主动思考微观世界与人类的密切联系。整个讲座氛围热烈,同学们认真聆听、积极记录,在轻松愉快的氛围中收获了丰富的微生物知识,感受到了生命科学的神奇魅力。

此次科普讲座为同学们搭建了一个接触前沿科学的平台,不仅普及了微生物学基础知识,更培养了同学们的科学探究精神和创新思维。作为科技节的重要组成部分,活动有效激发了学生爱科学、学科学、用科学的热情,为校园营造了浓厚的科学文化氛围。后续,我校将继续开展各类科技科普活动,助力学生全面发展,点亮科学梦想。
供稿:科信组
撰稿:尹佳宜
照片:姚春玲 尹佳宜
初审:吴莉荣
复审:董仕峰
终审:李荔萍